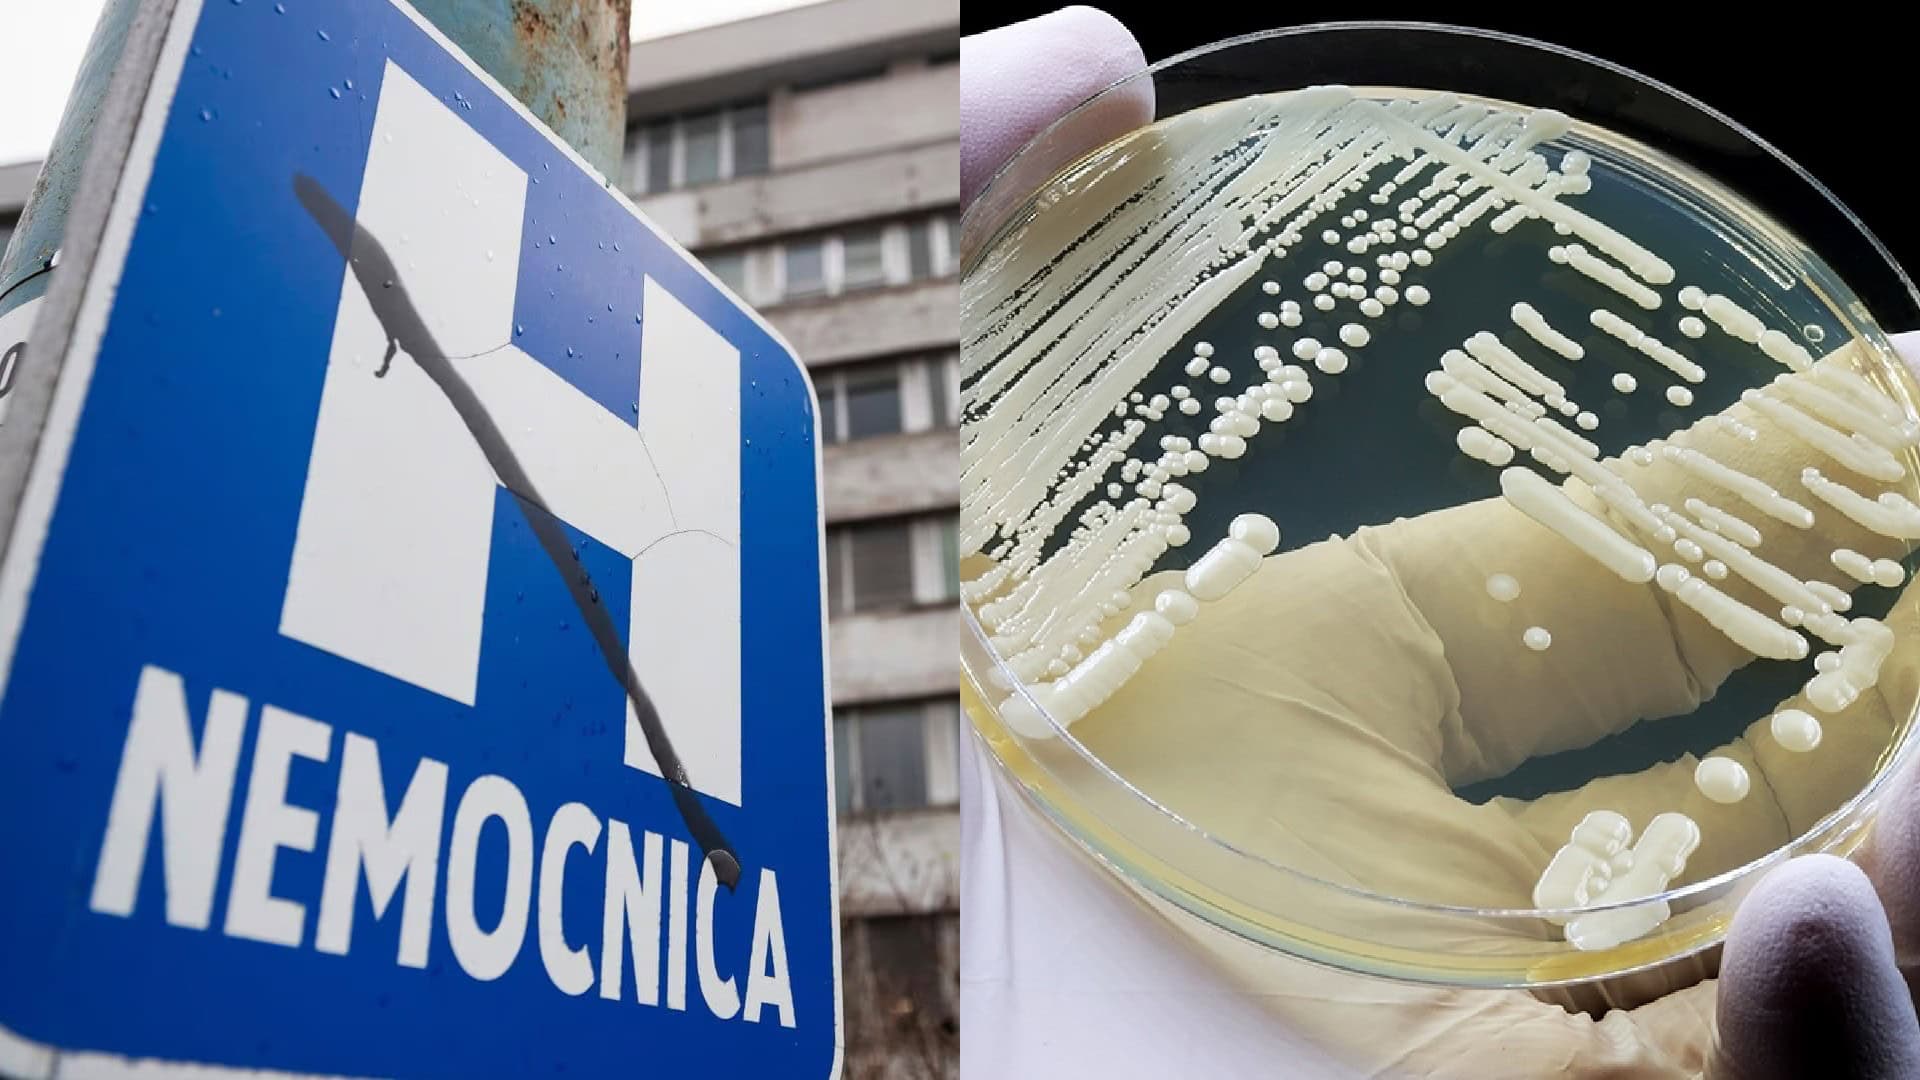
candida auris

Zabíja 3 z 5 pacientov. Pri Slovensku zachytili nebezpečnú kvasinku, odborníci varujú
- Nebezpečný mikroorganizmus Candida auris sa už vyskytol v susedných krajinách
- Kvasinka odolná voči liekom môže preniknúť aj do slovenských nemocníc
Nebezpečný mikroorganizmus s názvom Candida auris začína znepokojovať zdravotnícke systémy po celom svete. Táto odolná kvasinka, ktorú Svetová zdravotnícka organizácia (WHO) označila za jednu z najnebezpečnejších hubových infekcií súčasnosti, sa v posledných rokoch rozšírila na všetky kontinenty s výnimkou Antarktídy.
Prvé potvrdené prípady hlási aj Česká republika, kde sa infekcia objavila u pacientov s oslabenou imunitou. Na Slovensku zatiaľ podľa oficiálnych zdrojov potvrdený výskyt nebol.
„Hubové infekcie sa stále viac šíria a sú čoraz odolnejšie voči liečbe, čím sa stávajú celosvetovým problémom v oblasti verejného zdravia,“ uviedla Hanan Balkhy, zástupkyňa generálneho riaditeľa WHO pre antimikrobiálnu rezistenciu.
Candida auris bola po prvý raz identifikovaná v roku 2009 v Japonsku, keď bola izolovaná z ušného kanála pacientky. Odvtedy prešla rýchlym vývojom a adaptáciou, vďaka čomu sa dnes považuje za jeden z najodolnejších patogénov v nemocničnom prostredí.
Vysoká úmrtnosť, nulová odpoveď na lieky
Jednou z najznepokojujúcejších vlastností Candidy auris je jej extrémna rezistencia voči dostupným antimykotikám aj bežne používaným dezinfekčným prostriedkom. Zatiaľ neexistuje účinná liečba, ktorá by infekciu spoľahlivo zvládla. WHO preto zaradila túto kvasinku medzi 19 najnebezpečnejších húb súčasnosti.
Infekcia je obzvlášť riziková pre pacientov so zníženou imunitou – napríklad starších ľudí, pacientov po onkologickej liečbe či osoby s chronickými ochoreniami. Odhadovaná úmrtnosť dosahuje až 60 %, najmä pri prípadoch systémovej infekcie, keď kvasinka prenikne do krvného obehu a spôsobí sepsu alebo zlyhanie orgánov, píše web CNN Prima News.
Skrytá v nemocniciach, prenáša sa cez povrchy aj personál
Candida auris sa šíri najmä v nemocničnom prostredí, kde prežíva na kontaminovaných povrchoch, prístrojoch alebo dokonca na rukách zdravotníckeho personálu. Infekcia môže byť veľmi nenápadná, a práve preto si vyslúžila označenie „tichý zabijak“. Prvé príznaky sú nešpecifické – horúčka, zimnica, slabosť – a nezriedka sa zamieňajú za bakteriálne ochorenie, na ktoré nezaberajú antibiotiká.
Ak sa včas nesprávne diagnostikuje, infekcia môže napáchať vážne škody. Navyše, jej schopnosť prežiť na povrchoch niekoľko dní až týždňov z nej robí mimoriadne odolného protivníka v boji o bezpečné nemocničné prostredie.
„Táto kvasinka je schopná infikovať centrálnu nervovú sústavu aj vnútorné orgány. V nemocniciach sa šíri cez kontakt s pacientmi, pomôckami aj prostredím,“ uviedol denník The Mirror US.
Prevencia je kľúčová, Slovensko by nemalo zaspať
Hoci Slovensko zatiaľ nehlási žiadny potvrdený prípad Candidy auris, odborníci varujú, že môže byť otázkou času, kedy sa objaví aj v našich zdravotníckych zariadeniach. Prevencia a pripravenosť sú preto kľúčové.
Medzi základné opatrenia patrí dôsledná hygiena rúk, používanie ochranných pomôcok, izolácia infikovaných pacientov a pravidelná dezinfekcia priestorov. V prípade podozrenia je nevyhnutné konať rýchlo – infekcia sa totiž môže šíriť veľmi potichu, ale mimoriadne efektívne.
Zatiaľ najvyšší výskyt v Európe bol hlásený v Španielsku, Taliansku a Grécku. V Nemecku lekári do roku 2022 diagnostikovali 27 prípadov. Ostatné susedné krajiny vrátane Rakúska, Poľska a Česka zatiaľ evidujú len jednotlivé prípady. Slovensko má však všetky predpoklady na to, aby sa pripravilo – kým ešte má čas.
Čítaj viac z kategórie: Hlavné správy a aktuality
Zdroje: WHO, CNN Prima NEWS, The Mirror









